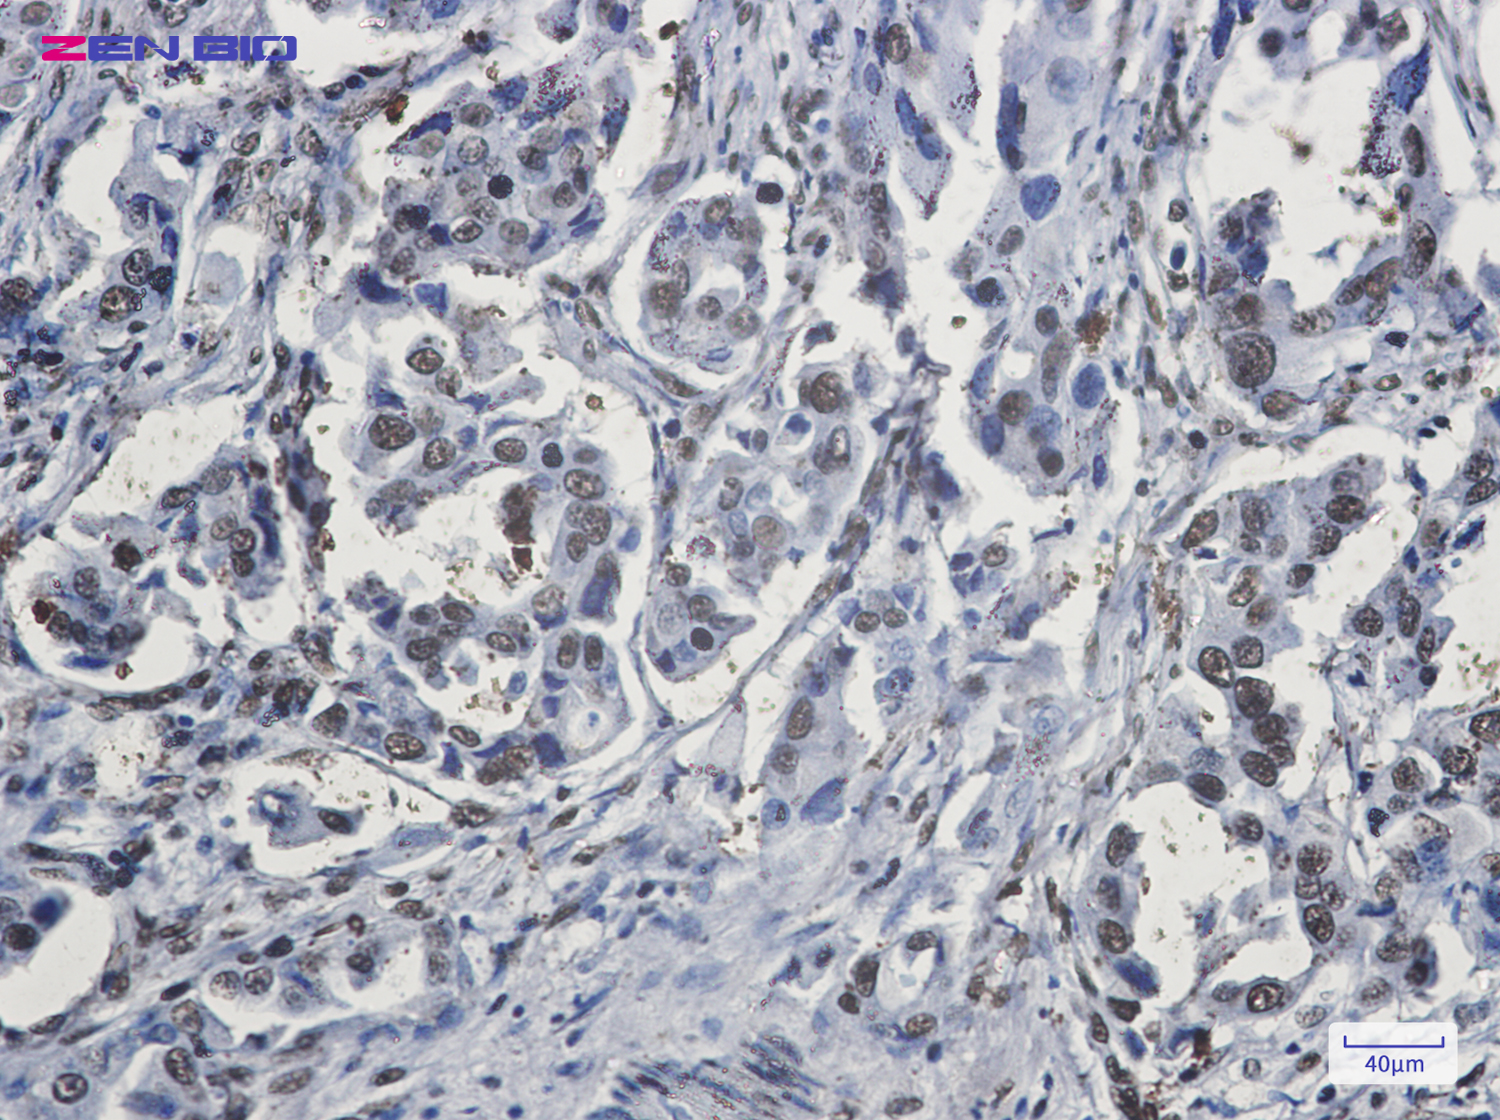
Immunohistochemistry of hnRNP G in paraffin-embedded Human lung cancer tissue using hnRNP G Rabbit pAb at dilution 1/20

-
Product Name
Anti-hnRNP G Rabbit antibody
- Documents
-
Description
hnRNP G Rabbit polyclonal antibody
-
Tested applications
WB, IHC-P, ICC/IF
-
Species reactivity
Human, Mouse, Rat
-
Alternative names
RNMX; HNRPG; HNRNPG; MRXS11; RBMXP1; RBMXRT; hnRNP-G antibody
-
Isotype
Rabbit IgG
-
Preparation
Antigen: A synthetic peptide of human hnRNP G
-
Clonality
Polyclonal
-
Formulation
Supplied in 50nM Tris-Glycine(pH 7.4), 0.15M Nacl, 40%Glycerol, 0.01% sodium azide and 0.05% BSA.
-
Storage instructions
Store at -20°C. Stable for 12 months from date of receipt.
-
Applications
WB: 1/1000
IHC: 1/20-1/100
ICC/IF: 1/20-1/50
-
Validations

Western blot detection of hnRNP G in K562,Hela cell lysates using hnRNP G Rabbit pAb(1:1000 diluted).Predicted band size:42kDa.Observed band size:42kDa.
Immunohistochemistry of hnRNP G in paraffin-embedded Human lung cancer tissue using hnRNP G Rabbit pAb at dilution 1/20
-
Background
Swiss-Prot Acc.P38159.RNA-binding protein that plays several role in the regulation of pre- and post-transcriptional processes. Implicated in tissue-specific regulation of gene transcription and alternative splicing of several pre-mRNAs. Binds to and stimulates transcription from the tumor suppressor TXNIP gene promoter; may thus be involved in tumor suppression. When associated with SAFB, binds to and stimulates transcription from the SREBF1 promoter. Associates with nascent mRNAs transcribed by RNA polymerase II. Component of the supraspliceosome complex that regulates pre-mRNA alternative splice site selection. Can either activate or suppress exon inclusion; acts additively with TRA2B to promote exon 7 inclusion of the survival motor neuron SMN2. Represses the splicing of MAPT/Tau exon 10. Binds preferentially to single-stranded 5'-CC[A/C]-rich RNA sequence motifs localized in a single-stranded conformation; probably binds RNA as a homodimer. Binds non-specifically to pre-mRNAs. Plays also a role in the cytoplasmic TNFR1 trafficking pathways; promotes both the IL-1-beta-mediated inducible proteolytic cleavage of TNFR1 ectodomains and the release of TNFR1 exosome-like vesicles to the extracellular compartment.
Related Products / Services
Please note: All products are "FOR RESEARCH USE ONLY AND ARE NOT INTENDED FOR DIAGNOSTIC OR THERAPEUTIC USE"
